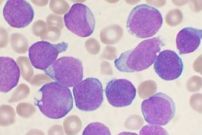
לוקמיה.jpg

עמוד ראשי
מתוך ויקירפואה
תורמי תוכןלכל תורמי התוכן >

איגוד רופאי המשפחה בישראל

אגודה ישראלית לסוכרת

פקולטה לרפואה ע"ש סאקלר

האיגוד לאונקולוגיה קלינית ורדיותרפיה

היחידה למחלות זיהומיות
עורכים נבחרים לכל העורכים >
ויקי ספרים לכל הספרים >


 כניסה
כניסה  עקבו אחרינו בפייסבוק
עקבו אחרינו בפייסבוק